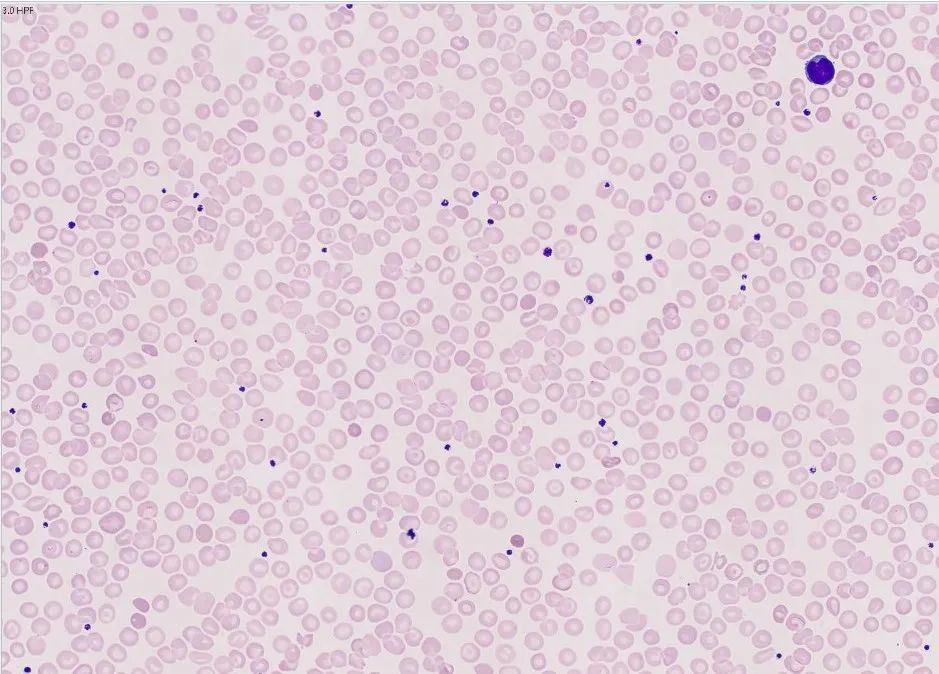

单位 | 河北医科大学第三医院检验科
01 前 言
地中海贫血(简称地贫)又称海洋性贫血、珠蛋白生成障碍性贫血,因最早发现于地中海沿岸城市而得名。是一种由于珠蛋白基因缺失或突变导致肽链合成障碍而引起的溶血性贫血[1],是我国南方地区常见的单基因遗传病,在我国的广东和广西两省发病率最高。近年来随着改革开放和经济发展,人口流动大,低发病率地区也频现病例。
02 案例经过
血液科患者,男,18岁,大一学生,籍贯河北保定,巩膜轻度黄染,半年前因体检发现胆红素血增高,曾就诊于肝胆科和血液科,未找到具体原因,建议观察,近日来我院复查就诊。实验室检查结果如下:
血常规结果(图1)显示,该患者红细胞体积(MCV)、平均血红蛋白量(MCH)和平均血红蛋白含量(MCHC)均减低,提示小细胞低色素性贫血;红细胞计数(RBC)和网织红细胞绝对值(RET#)升高,提示骨髓造血活跃。

图1 血常规结果
随即查看仪器结果,显示血小板直方图异常且报警提示小细胞性红细胞,血小板直方图右侧以较大斜率抬起,呈现拖尾现象(图2)。正常血小板直方图应呈现偏态分布的单峰光滑曲线,且大小在2~30fl。当标本存在小红细胞、巨大血小板和血小板聚集等情况时,会出现翘尾的现象。

图2 仪器结果和报警信息
因触犯复检规则(MCV小于75Fl),进行外周血细胞形态学检查,血涂片可见红细胞大小不一,计数900个红细胞,靶形红细胞约占10%(见图3)。
图3 外周血涂片
生化结果(图4)显示总胆红素(TBIL)和直接胆红素(DBIL)升高,提示大量的红细胞被破坏而引起。

图4 生化结果
综合实验室检查分析,靶形红细胞常见于各种低色素贫血,在地贫时尤易常见。且地贫属于溶血性贫血,患者的TBIL会出现升高的情况。而常规检查仅能对该疾病进行初筛,结合患者的家族史,其母亲胆红素轻度升高,于是建议临床医生和患者完善地中海贫血基因检测,最终该患者确诊为β珠蛋白基因中IVS-Ⅱ-654(C>T)位点杂合突变的轻型β-地中海贫血(图5)。

图5 基因检测结果
03 案例分析
根据突变基因类型不同,地中海贫血主要可分为α-地贫和β-地贫两类。根据临床症状,α-地贫可分为静止型、轻型、中型和重型;β-地贫可分为轻型、中型和重型[2]。
β-地中海贫血一般是由于β基因点突变导致β肽链合成减少,多余的α肽链沉积在红细胞膜上,造成红细胞破坏[3]。轻型β-地贫患者的血常规有异常,但对生活影响较少。中型β-地贫患者由于基因突变类型不一,其贫血程度也有所不同。β-地贫患者在胎儿期并无异常,但出生之后发病越早,病情越重。重型β-地贫患者一般会有贫血、黄疸、肝脾肿大和典型的地中海贫血特殊面容,若不及时治疗,可能在五岁前死亡。
由于重型地中海贫血无法有效治疗,生活质量差,患者对于家庭和社会都是严重的负担,因此通过地中海贫血筛查和诊断,防止重型地贫患儿的出生是目前世界上最为有效的措施。
在临床检验中,通过对血常规的结果我们可以初步对地贫进行筛查。(1)MCV<80fl,MCH<27fl为首要表现;(2)根据地中海贫血的筛查公式:RBC×100/MCV的计算值>7和MCV/RBC的计算值<13时,提示地中海贫血的可能性大;(3)外周血涂片中红细胞大小不均且可见靶形红细胞时,应考虑地中海贫血。
此外,还应结合患者的生源地和家族史,进行进一步的如红细胞渗透脆性实验、血红蛋白电泳和地中海贫血基因检测。其中,地中海贫血基因检测是诊断地贫的金标准。
04 总 结
本例患者MCV和MCH均偏低,根据公式计算RBC×100/MCV为10.73,MCV/RBC为9.32,外周血涂片可见靶形红细胞。结合患者的家族史和地中海贫血基因检测,确诊为β-地中海贫血。
血常规对地贫的初筛和鉴别诊断有着重要的作用,我们作为检验人,对检查结果要有高度敏感性,提高自身的专业素养,避免漏诊和误诊,从而能更好的服务临床和患者。
【参考文献】
[1] Muncie H L, Campbell J. Alpha and beta thalassemia[J]. American Family Physician, 2009, 80(4):339-344.
[2]杜传书.地中海贫血研究的现状与未来[J].中华医学遗传学杂志, 1996(5).DOI: CNKI: SUN: ZHYC.0.1996-05-000.
[3]王燕燕,李晓辉,徐西华.地中海贫血诊治进展与我国现状[J].中国实用儿科杂志, 2013, 28(6):4. DOI: CNKI: SUN: ZSEK.0.2013-06-030.